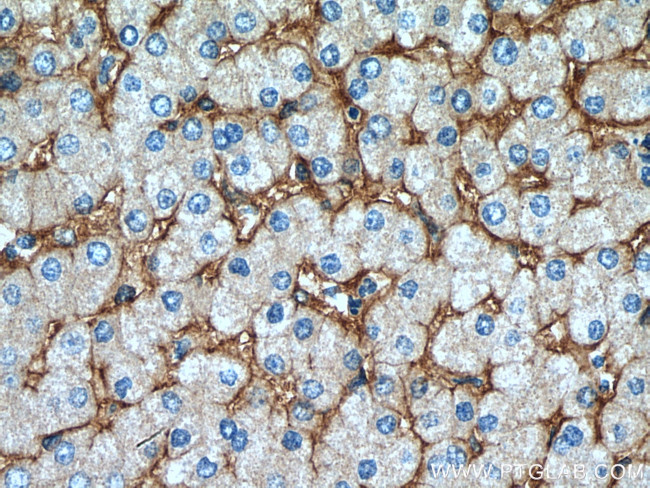
Integrin alpha-1 Antibody in Immunohistochemistry (Paraffin) (IHC (P))
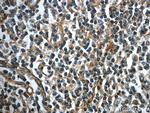
Integrin alpha-1 Antibody in Immunohistochemistry (Paraffin) (IHC (P))

Search
Proteintech
Integrin alpha-1 Polyclonal Antibody
{{$productOrderCtrl.translations['antibody.pdp.commerceCard.promotion.promotions']}}
{{$productOrderCtrl.translations['antibody.pdp.commerceCard.promotion.viewpromo']}}
{{$productOrderCtrl.translations['antibody.pdp.commerceCard.promotion.promocode']}}: {{promo.promoCode}} {{promo.promoTitle}} {{promo.promoDescription}}. {{$productOrderCtrl.translations['antibody.pdp.commerceCard.promotion.learnmore']}}
产品信息
22146-1-AP
种属反应
已发表种属
宿主/亚型
分类
类型
抗原
偶联物
形式
浓度
规格
纯化类型
保存液
内含物
保存条件
运输条件
产品详细信息
Immunogen sequence: DSLPNSVHE YIPFAKDCGN KEKCISDLSL HVATTEKDLL IVRSQNDKFN VSLTVKNTKD SAYNTRTIVH YSPNLVFSGI EAIQKDSCES NHNITCKVGY PFLRRGEMVT FKILFQFNTS YLMENVTIYL SATSDSEEPP ETLSDNVVNI SIPVKYEVGL QFYSSASEYH ISIAANETVP EVINSTEDIG NEINIFYLIR KSGSFPMPEL KLSISFPNMT SNGYPVLYPT GLSSSENANC RPHIFEDPFS INSGKKMTTS TDHLKRGTIL DCNTCKFATI TCNLTSSDIS QVNVSLILWK PTFIKSYFSS LNLTIRGELR SENASLVLSS SNQKRELAIQ ISKDGLPGRV P (792-1141 aa encoded by BC137121)
靶标信息
Integrin alpha 1 (ITGA1) chain associates with the beta 1 (ITGB1) chain to form a heterodimer that functions as a dual laminin/collagen receptor in neural cells and hematopoietic cells. ITGA1 has a 206-amino acid I domain in its N-terminal half, followed by 3 divalent cation-binding sites and a C-terminal transmembrane domain with a short cytoplasmic tail. It also has 28 potential N-glycosylation sites. Human ITGA1 was expressed in a mouse fibroblast cell line as a 180-kD protein. ITGA1 is involved in the early remodeling of osteoarthritic cartilage and plays an essential role in the regulation of mesenchymal stem cell proliferation and cartilage production. It also plays an essential role in the regulation of MSC proliferation and cartilage production.
仅用于科研。不用于诊断过程。未经明确授权不得转售。
生物信息学
蛋白别名: CD49 antigen-like family member A; CD49a; Integrin alpha-1; Laminin and collagen receptor; unnamed protein product; very late activation protein 1; very late antigen-1; VLA-1
基因别名: CD49a; ITGA1; VLA1
UniProt ID: (Human) P56199
Entrez Gene ID: (Human) 3672